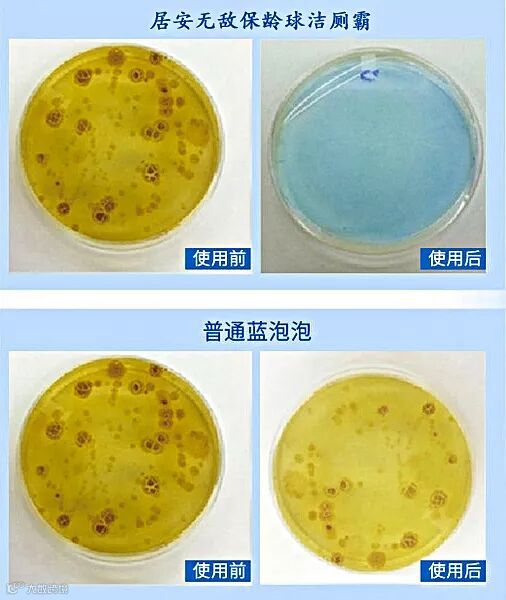

平日里的生活,除了吃饭和睡觉之外。必不缺少的当然还有上厕所啦~
世界厕所组织WTO (World Toilet Organization)早前就有统计过,平均我们每天会上厕所6-8次,一年约2500次。

也就是说,你的一生会有很大一部分时间都在与马桶亲密接触!
但是你知道吗?刚刚冲完的马桶内壁上还会残留10万多个细菌。

时间一长就很容易形成黄斑污渍,也就让霉菌和细菌更加放肆的生长。然后漂浮在空气中的每一个角落,散发出令人作呕的难闻气味。

所以马桶的卫生就很重要了啊,不管是看的见的污垢还是看不见的细菌,都需要被消灭的干干净净!
不少人家里都会在马桶水箱里放一个“蓝泡泡”。但是这种普通的蓝色小块使用起来真的是槽点满满。

所以今天小编就给大家带来了一个能够完全溶解,清洁污垢更彻底,丢进去180天都不用管,甚至还能带走细菌的洁厕霸~

30S了解它的神奇之处:
1、浓缩凝胶配方使用周期长,微孔释放完全溶解无残留不挂壁,深层污垢也能轻松清理!
2、自然花果芬芳,洁净又安全,不掉色也不沾手,让你的马桶焕然一新!
3、丢进去1瓶半年都不用管,能够使用长达2100次,持续保持很好的清洁效果~


把“保龄球”放进马桶水箱?
管道污垢都能被清理干净
不少公共厕所坑位里面都会贴有“来也匆匆去也冲冲”的标识。
摁下后面的冲厕摁扭后,就会看到一汪蓝色的水流涌出,可以说是很赏心悦目了。

当然,它的实际作用可并不是为了美观。而是为了可以卷走更多的污垢和细菌,保持干净的环境。
但是不少人家中常备的普通蓝泡泡,撕开后很容易掉色粘的满手都是,而且还会挂在马桶侧壁上,冲不干净不说还会有残留!

丢进马桶后,用了不到一周可能就要换新的,根本用不了多少天。真的太不禁用了!

一买就得买一箱,囤在家里。不仅占地方,还很容易受潮。

突破传统马桶清洁
完全溶解清洁更彻底
为什么普通蓝泡泡使用起来会有这么多的弊端呢?这就要从源头成分说起啦~
普通蓝泡泡的成分大部分都是由各种清洁剂、香精、染料构成。成本低且不耐用,所以难免产生挂壁等情况。

而居安无敌保龄球洁厕霸,主要成分则是柠檬酸以及各种有机酸。

所以能够完美的在水中溶解,发生酸性反应。从而去除巩固的碱性污渍。

采用浓缩凝胶配方,搭配科学缓释技术,才得以在放入水箱后发挥强效的清洁作用。

放入后,就能看到蓝色的清洁液体从微孔中渗透出来,溶解的也很彻底,很快就扩散到了整个水面。

免去刷马桶的麻烦,不管多脏的污垢和尿碱也都能轻松被冲走。

为了看它到底能不能清洗掉脏污垢,小编爬了好几层楼才找到了一个很脏的马桶。

然后我们把居安无敌保龄球洁厕霸放到了水箱里面,摁下冲水开关。

蓝色的清洁剂伴随着水流的涌动,竟然连马桶的边边角角都清理的很干净。

再也不用担心家里的马桶会结出厚厚的尿垢了,普通蓝泡泡和长柄刷都可以扔掉了。

温和的清洁材质不仅能够完全溶解,而且还能在马桶和水箱上形成一层保护膜。

所以在带走脏污让马桶焕然一新的同时,也并不会伤害马桶的水箱和釉面。

独特的浓缩凝胶配方缓释出的蓝色液体也更加持久,让你每次如厕后都能拥有好心情~


你家厕所怎么这么臭?
有了它就能芬芳四季
毕竟人有三急,所以我们每天都要上厕所。但为什么有时候一进厕所就会闻到令人作呕的味道?
这还不是因为你家马桶传来的?你以为上完厕所随便一冲就完了吗?

当然不行啊,马桶内壁上多的是你看的见的污垢和看不见的各种细菌,脏污细菌多了自然味道就难闻了起来啊。

如果你家厕所味道一直很难闻,那你可就要注意了。因为很有可能,空气中都已经开始飘散着各种细菌了。
尤其抵抗力差的,一不小心就会引发腹泻、发热、呕吐等急性症状。

有了居安无敌保龄球洁厕霸,就不用担心这些问题啦~

因为有机酸成分不仅具有很强的清洁能力,还能消灭马桶内隐藏的细菌,洁净又安全。

使用一段时间后,细菌都变少了很多呢。而普通蓝泡泡使用过后并没有明显变化哦~
不仅马桶变得干净,还能卷走细菌。冲一次马桶≈刷一次马桶+镀一层保护膜,简直不要太划算!

焕然一新的马桶还会散发出芬芳的迷人香气,整个厕所都不再发臭了呢~

再也不用费劲吧啦的收拾马桶了,也完全不用担心被冲出的细菌感染到了。

居安无敌洁厕霸可以说是从根源解决了问题,感觉空气中都弥漫着幸福的味道,生活质量也提高了一大截!

懒人福利1瓶能用6个月
持久清洁环保又节约
颠覆传统设计的保龄球外形,加上实在的分量,真的有点像从保龄球馆拎出来似的。

可别小看就这个外观,可是获得了专利的哦


从外表上看可能觉得里面没什么“内涵”,但刨开里面,那可是满满的浓缩凝胶啊!

再加上微孔缓释技术,所以能够长期稳定的缓缓释出,更加耐用。一瓶更比80粒蓝泡泡要强哦~

轻松一丢,半年都不用管它。一瓶下来平均能用2100次,180天。

小编亲测,用了150天,蓝色的清洁液体也没有变很淡,马桶一直都很干净。

质量方面也是更不用担心,毕竟是每天会和你的“屁屁”亲密接触的,怎么能马虎?
质检报告了解一下~

操作起来更是非常方便,只需撕下侧面温馨的贴纸,就能使用了~

然后再丢进水箱,避开出水口竖直放着,就能让它带走脏污和细菌啦。

精致的外观下,每一刻都无不在散发着迷人的芬芳气息,给你带来更加卫生的如厕环境和洁净一新的干净马桶~

所以再也不用担心马桶会变得“又脏又臭”,让人望而却步了。用了居安无敌保龄球洁厕霸就能让你每天拥有好心情~

你家又脏又臭伴随“感染”风险的马桶,还怎么坐的下去?
有了居安无敌保龄球洁厕霸,就能让你的马桶焕然一新,每天都能清新又干净!还不快“剁手”?

原价79元2瓶,现在购买仅需49元就能买到2瓶!真的太划算了!
1瓶可以使用1200次,180天,也就是半年啦。现在买两瓶的话今年一年都不用买了~

和普通蓝泡泡相比,浓缩的就是强。一瓶更能抵过80粒,真的超级省啊。

要知道普通蓝泡泡一块最多也就用上10天,而且还很不均匀很容易就挂在马桶内壁,时间一长还受潮变软根本不能用。

所以为了让大家都能拥有更干净更卫生的马桶,今天小编还为大家争取到了最大福利哦~

现在购买4瓶更超值划算哦,只需89元。就能让厕所洁净一整年,用不完还可以送朋友,简直不要太实惠!

每天只需1毛钱!
简直就是不要钱啊
马桶洁净如新每天都能好心情
生活质量也高了一大步
还不快喊好基友们一起抢?

声明:本文为广告信息,解释权归广告内容提供方所有。所有内容和图片由广告内容提供方提供,涉及版权、产品服务和质量等所有信息和一切法律责任由广告内容提供方负责,与本平台无关。
本站仅为内容展现平台,并非交易内容的提供者。
更多更优惠好货等你来抢!
↓↓↓点击或者长按识别二维码进入商城↓↓↓
↓↓【双11预热开启】↓↓




